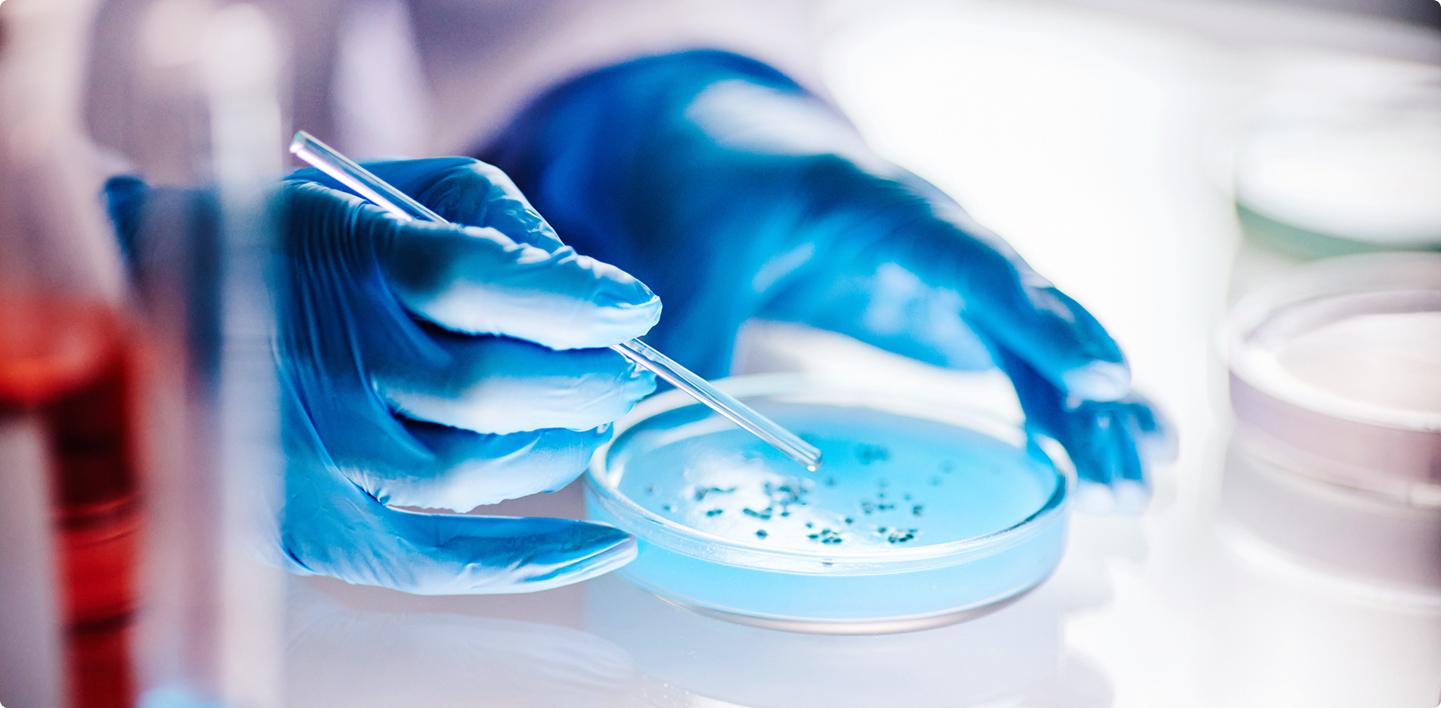

ユニット概要
オホーツク地域に特徴的な素材の利用法や、地域産業における課題を、化学を基盤とするバイオテクノロジーおよび食品工学を駆使して解決し、人間性と社会性を備えた技術者として活躍出来る能力を養成するユニットです。

選択可能分野
2年次の選択した専門分野によっては履修できません。進みたいユニットを視野に入れて進路を決定しましょう。




教員メッセージ

学べる主な内容

- 微生物学
- 食品加工
- 食品衛生
- 植物科学
- ポリマー
- ハッカ
- バイオテクノロジー
求める人材

- 医薬品、サプリメントに興味関心がある
- バイオテクノロジーに興味関心がある
- 食の安全を守りたい
- 工学の力で一次産業を支えたい
- 地域産業の発展に貢献したい
活躍が期待される主なフィールド
北見工業大学 大学院博士課程
- 応用化学プログラム
- データサイエンスプログラム
- 他大学院
就職先
- 食品製造業
- 化学工業
- 食品会社
- 製薬会社
- 医療品業界
- 化粧品業界
- 農業ビジネス
- 食品流通
- 公務員

カリキュラム内容
学修内容
生体材料や構造材などの高分子材料、様々な有機化合物とその構造解析法、天然に存在する有機物の化学構造や生物活性、食品の衛生管理・安全管理、植物性食品・動物性食品などの加工原理や貯蔵方法、ヒト消化器官の構造と生理機能、栄養素の代謝、食品素材への微生物の影響、健康維持や生活習慣病など、バイオテクノロジーや食品工学に関する幅広い応用知識、問題解決能力の育成を重視したカリキュラムとしています。関連する実験科目も多く配置し、様々な視点から応用化学・生物・食品分野に関する総合的な学習が可能です。また、オホーツク地域に特徴的な素材・植物を利活用し、地域や社会における課題解決ができる専門技術者として社会で活躍できる能力を養います。

ピックアップカリキュラム
微生物学
微生物は、感染症、地球規模での物質循環、バイオ産業などに関与しています。本講義ではそのような微生物の生理、遺伝、代謝などの基礎知識ならびに利用技術に関して講義します。

食品栄養生理学
食品はタンパク質、炭水化物、脂質などの栄養素で成り立っています。本講義では、消化器系の生理機能、栄養素の消化・吸収・体内運搬、栄養素の代謝、生活習慣病との関連について学びます。
その他のカリキュラム
- 生物有機化学
- 高分子化学
- 有機構造解析
- 生物化学工学
- 食品衛生学
- 食品加工貯蔵学I
- 食品栄養生理学
- 生命化学・食品科学実験I
- 有機化学III
- 天然物化学
- 食品工学
- 食品加工貯蔵学II
- 食品機能学
- 生命化学・食品科学実験II
詳細はシラバス検索をご利用ください
シラバス検索

研究室ピックアップ

植物分子工学研究室
植物が常に変化する生育環境に適応できる仕組みの研究を行っています。また、オホーツクのハッカ栽培の歴史や技術に学び、薬用・香料植物の育成に役立つような植物研究も行っています。
准教授:陽川 憲

バイオプロセス工学研究室
微生物の分離・解析・育種・培養技術について研究しています。人工知能の導入により、バイオ生産プロセスのスマート化、効率化を目指します。次世代バイオ材料・食品・医薬品分野での活躍が期待されます。
教授:小西 正朗

食品栄養化学研究室
機能性食品の開発を目指し、培養細胞を用いた基礎研究を行っています。オホーツク地域の食材に含まれるポリフェノールなどの生理活性成分の抗アレルギーおよび抗炎症作用機序を解明することで、食と医療の発展に貢献します。
教授:新井 博文

高分子化学、生体分子化学研究室
高分子には、プラスチックやゴムなどの合成高分子や、タンパク質、核酸、多糖などの天然高分子があります。モノマーの構造や結合の順序、高分子の長さを変えて、高機能な高分子材料を作ることができます。プラスチック光学材料やバイオマスを利用した多糖類の合成および機能について研究しています。
准教授:服部 和幸


